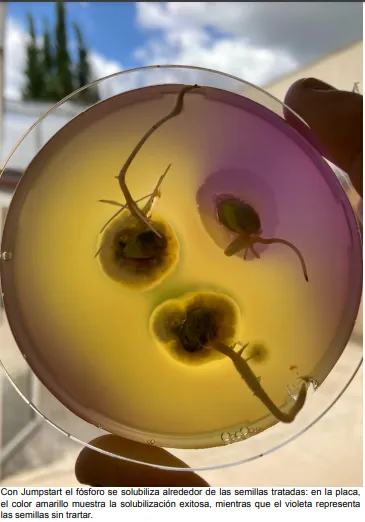
NOVOZYMES

Inoculación 2.0: plus de 400 kg/ha de soja combinando un bioestimulante al momento de inocular la semilla
Darío Fariña


En un esfuerzo continuo por promover la innovación y la sostenibilidad en la agricultura, Novozymes lanza al mercado en forma masiva su biofertilizante Jumpstart líquido. Se trata de un bioestimulante a base de Penicillium bilaiae, un hongo que a partir de sus exudados permite la solubilización de nutrientes, destacándose el fósforo por su impacto en el establecimiento del cultivo.
La Dra. Gisella Santella, Gerente de Desarrollo de Novozymes, comentó que "Nuestro compromiso con la innovación y la sostenibilidad se respalda con datos sólidos y consistentes. Los casi 400 kg por hectárea adicionales en rendimiento, confirmados durante tres campañas de ensayos a campo en 41 sitios, demuestran que la biotecnología tiene mucho para aportar en términos de sostenibilidad y productividad”.
La solubilización del fósforo mejora la absorción y utilización de este nutriente por parte de las plantas de soja, lo que se traduce en un aumento considerable del rendimiento en comparación con los métodos convencionales de inoculación. El mecanismo de acción de este hongo que crece asociado a la raíz es secretar ácidos orgánicos permitiendo así que depósitos de fósforo y otros nutrientes puedan pasar a formas disponibles para las plantas y ser absorbidos por las raíces.
Según la Asociación Civil FERTILIZAR, el 70% de los lotes de soja no cubren la necesidad de fósforo, y este déficit puede explicar hasta el 40% de la pérdida de producción. Basándose en estos datos la doctora Santella señaló que: “Es de vital importancia maximizar la disponibilidad de este nutriente que, sumado al nitrógeno de la fijación biológica, permitan trabajar con estrategias balanceadas de nutrición integral para maximizar los rendimientos de los cultivos”.
Además de una mayor disponibilidad de nutrientes, los resultados a campo de lotes tratados con Jumpstart dan cuenta de una mayor nodulación en la raíz principal lo cual impacta directamente en el aprovechamiento de otro nutriente clave como es el nitrógeno. De esta manera, esta nueva tecnología para tratamiento de semillas permite aumentar la productividad del cultivo conjuntamente con la fijación del carbono en el suelo.
En cuanto a la operatividad, este bioestimulante se destaca por su compatibilidad con los inoculantes y fungicidas más usados en el mercado, además de ofrecer la posibilidad de pretratar las semillas 45 días antes de la siembra del cultivo. En este sentido, Santella enfatiza: “Recordemos que las buenas prácticas durante el tratamiento de semillas es un punto clave para lograr maximizar el rendimiento del cultivo”.
Acerca de Novozymes. Es el líder mundial en soluciones biológicas. Junto con los clientes, colaboradores y la comunidad global, mejoramos el desempeño industrial, al tiempo que preservamos los recursos del planeta y ayudamos a construir una vida mejor. Como el mayor proveedor del mundo de tecnologías enzimáticas y microbianas, nuestra innovación biológica permite obtener mayores rendimientos agrícolas, lavado a baja temperatura, una producción que ahorra energía, combustibles renovables y muchos otros beneficios de los que dependemos en el presente y dependeremos en el futuro. Lo llamamos «Repensar el mañana». www.novozymes.com

Próximos remates








































